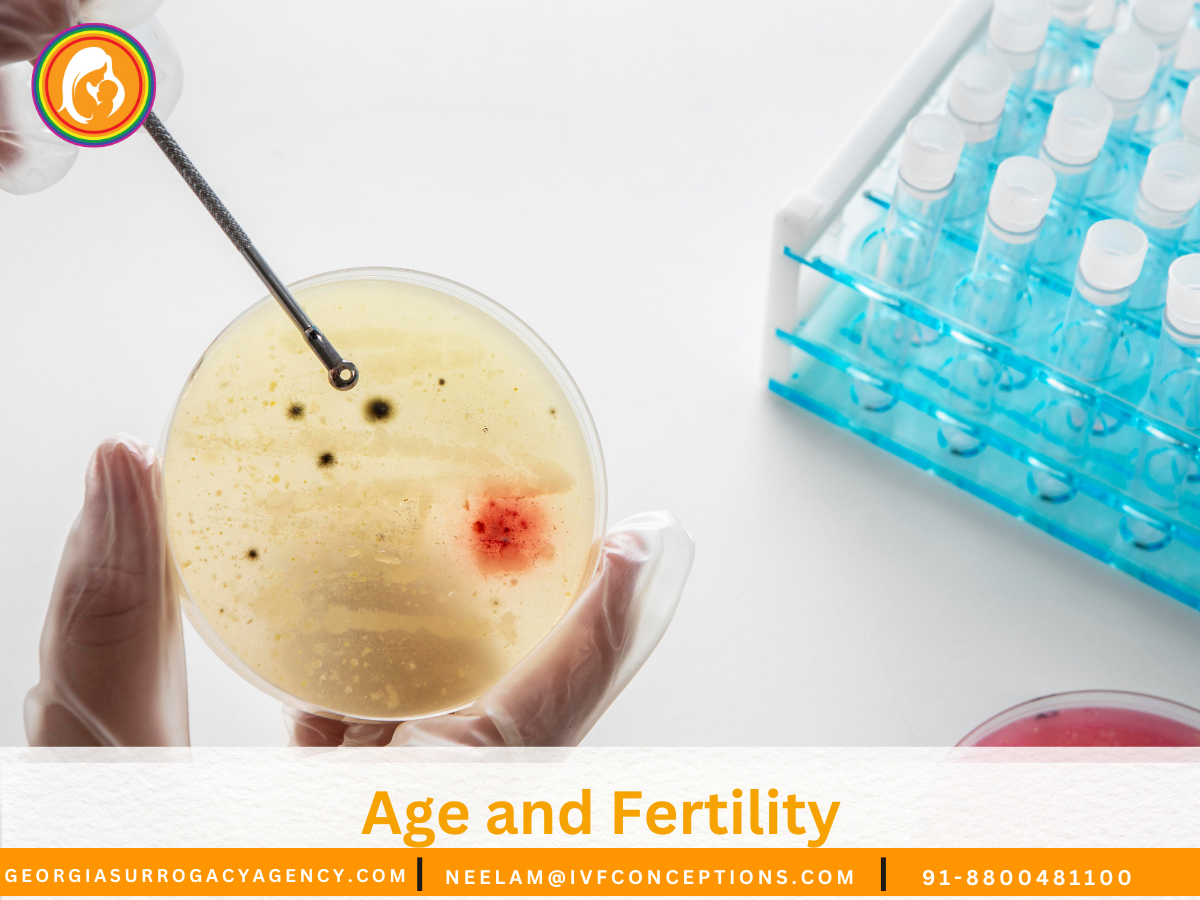
Age and Fertility: What to Expect at Every Stage of Life.

Understanding age and fertility can help individuals and couples make informed decisions about family planning. Fertility reaches its peak in the early 20s, when egg and sperm quality are highest, then gradually declines in the late 20s and early 30s. After 35, women may experience a sharper drop in ovarian reserve and embryo quality, while men may see decreased motility and increased DNA fragmentation in sperm as they age.
By the early 40s, natural conception becomes significantly harder, and the risk of miscarriage and chromosomal conditions increases. While assisted reproductive options like IVF, egg or sperm freezing, and surrogacy can support later-life parenthood, knowing how fertility changes over time allows for better planning, realistic expectations, and timely medical guidance.
Key Takeaways
- Fertility and aging differ by sex: ovarian reserve declines earlier; male fertility changes more gradually.
- Females are born with a finite number of eggs; only about 300 are ovulated in a lifetime.
- Declines in egg quantity and quality drive maternal age impact on fertility well before menopause.
- Delaying childbearing increases the chance of age-related infertility and the need for preservation or ART.
- Age affects natural conception, miscarriage risk, chromosomal abnormality rates, and treatment success.
📞 Get in Touch for a Free Surrogacy Consultation
📱 +91-8800481100 (WhatsApp | LINE | Viber)
📧 neelam@ivfconceptions.com
🌐 www.georgiasurrogacyagency.com

Understanding age and fertility: biology of reproductive aging
As we age, our bodies change in ways that impact family planning. Both men and women experience these changes. Key factors include the number and quality of eggs and sperm, affecting our chances of getting pregnant.
How ovarian reserve and egg quality change over time
Women are born with millions of follicles, but by puberty, this number drops to 300,000–500,000. Only about 300 eggs are released in a lifetime. Follicles continue to be lost, whether we’re pregnant, using birth control, or getting fertility treatments.
By the mid-to-late 30s, ovarian reserve plummets. Follicle counts are much lower by age 37. Follicles become less responsive to hormones, making it harder to get pregnant.
Tests like day-3 FSH and AMH can hint at lower reserve. But none can guarantee pregnancy.
Egg quality and age decline together. Chromosomal issues increase with age, leading to failed pregnancies or birth defects. Egg quality drops sharply in the mid-to-late 30s. Age is the best indicator of egg quality.
Male reproductive aging and sperm changes
Men produce sperm throughout their lives, but quality and quantity decline with age. Sperm motility, shape, and volume decrease over time. Testicles may also shrink and soften.
Older men face a slight increase in genetic changes in sperm and a bit less fertility. Major issues become more common after 60. Health problems and lifestyle choices like smoking can make these changes worse.
How the menstrual cycle and ovulation shift with age
Cycles are usually regular and ovulatory until the 30s (26–35 days). As reserve declines, cycles shorten to 21–25 days. Later, cycles may lengthen and become irregular.
Menstrual periods eventually stop, marking menopause after 12 months without a period. Lower reserve and poorer egg quality explain the decline in fertility with age. This results in lower chances of getting pregnant each cycle.
Older parents face higher risks of pregnancy complications like preeclampsia and preterm birth. Early counseling can help manage these risks, guiding decisions on testing, timing, and fertility preservation.
Fertility at different ages: decade-by-decade expectations
This guide helps understand how fertility changes with age. It explains when it’s best to try for a baby and the chances of success. It also talks about medical steps you might need to take.
Fertility in the late teens and twenties
The late teens and twenties are the best time to have a baby. Eggs are at their best quality, and there’s a strong ovarian reserve. The chance of getting pregnant is higher than in later years.
Pregnancy is safer in this age group. There are fewer problems with the chromosomes and lower miscarriage rates. It’s important to take care of yourself before trying to conceive.
Fertility in your 30s
In your 30s, fertility starts to decline, but it is still good. By ages 30–34, the chances of getting pregnant naturally are lower. Many people still get pregnant without help.
If you can’t get pregnant, you might need to see a doctor after 6–12 months. Talking about your chances of success and making a plan is helpful.
Fertility over 35 and into the 40s
After 35, fertility drops quickly. The chances of getting pregnant naturally decrease, and miscarriage and chromosomal problems increase. Doctors might suggest prenatal tests and diagnostic tests.
Assisted treatments like IUI and IVF are less effective with age. By the early 40s, the chance of getting pregnant with your own eggs is often less than 10%.
Late reproductive years and approaching menopause
In the 40s, the decline in fertility is more noticeable. Some women may experience early menopause or almost no eggs left. Using donor eggs for IVF can improve the chances of getting pregnant.
Menopause usually happens around 51, but fertility ends a few years earlier. Cycles become irregular, and the risk of not getting pregnant increases. Getting personalized advice and seeing a specialist is important.
| Age range | Typical fertility features | Estimated natural monthly pregnancy rate | Clinical considerations |
|---|---|---|---|
| Late teens–mid-20s | Peak egg quality, strong ovarian reserve | 20% or higher | Standard preconception care; low obstetric risk |
| 30–34 | Gradual decline begins | ~15–20% | Consider evaluation after 6–12 months if no pregnancy |
| 35–39 | Faster decline; higher miscarriage and chromosomal risk | ~10% or lower | Discuss prenatal screening and earlier evaluation |
| 40–44 | Marked reduction in egg quality and reserve | IVF with own eggs less effective; donor eggs often advised | |
| 45+ | Very low natural fertility; high obstetric risks | Strong counseling on alternatives: donor eggs, adoption, surrogacy |
Signs, testing, and diagnosing age-related infertility
When trying to conceive, subtle changes in cycle length, missed periods, or recurrent early losses can signal age-related infertility. You and your partner should watch for these signs while keeping lines of communication open with your clinician. Early recognition leads to clearer guidance about fertility testing and next steps.

- Standard definition: no pregnancy after 12 months of regular unprotected intercourse.
- If you are age 35 or older, begin evaluation after six months of trying.
- Begin evaluation immediately if there are obvious problems (no periods, severe pelvic pain, prior pelvic surgery) or if the partner has known concerns.
Ovarian reserve and hormone testing:
- Common tests include day-3 FSH and estradiol to screen baseline function.
- Antimüllerian hormone (AMH) offers an estimate of the remaining follicle pool and can be drawn any day of the cycle.
- Antral follicle count (AFC) via transvaginal ultrasound visualizes the small follicles and complements AMH.
- High day-3 FSH or estradiol may indicate reduced reserve. AMH and AFC give more detail but do not guarantee pregnancy.
- Some clinics use the clomiphene citrate challenge test (CCCT) for additional assessment.
Male fertility testing and semen analysis:
- Semen analysis evaluates sperm concentration, motility, and morphology and should be done early in the workup.
- Discuss male fertility and aging with the partner; sperm quality can decline with time and with some medical conditions.
- Refer to a urologist if results show persistent abnormalities or if there is erectile dysfunction. Test for contributing conditions such as low testosterone or chronic illness.
Diagnostic evaluation of reproductive anatomy and ovulation:
- Ovulation can be confirmed by cycle tracking, mid-luteal progesterone levels, ovulation predictor kits, or basal body temperature charts.
- Uterine and tubal studies include transvaginal ultrasound for fibroids or structural issues and hysterosalpingography (HSG) to check tubal patency.
- Sonohysterography or hysteroscopy helps find and treat intrauterine problems that affect implantation.
- Screening tests and genetic counseling are part of preconception care, especially for those with chronic disease or family history concerns.
Most of these assessments can be completed within six months. Use the results to guide shared decision-making about age-appropriate treatments, realistic success rates, and possible need for assisted reproductive technology. Clear counseling helps you weigh options based on diagnostic findings and personal goals.
Fertility preservation and planning options
Planning for future parenthood involves many choices. This includes medical options, timing, and personal priorities. We’ll look at common paths for fertility preservation and steps for planning. It’s important to have realistic expectations and get counseling before any procedure.

Egg freezing starts with ovarian stimulation using injectable medications. A transvaginal retrieval collects mature oocytes. These are then frozen for later use in IVF.
Success rates are highest when egg freezing happens at younger ages. As age at retrieval increases, outcomes decline. Counseling should cover costs, success rates, and how age affects future chances.
Embryo freezing involves fertilizing eggs with sperm before freezing. This method is well established and often has higher live birth rates. Legal and ethical matters, like consent and future disposition, need clear discussion.
Ovarian tissue freezing is another option, offered by some centers for patients facing treatments that threaten ovarian reserve. This option is still experimental and suitable for specific cases like cancer care. Quick referral is key when ovarian function is at risk.
For those over 40, options and success rates narrow. Egg freezing earlier in life improves later options. Without early preservation, third-party reproduction and donor eggs become primary choices. Counseling helps weigh medical, ethical, and social implications.
Fertility preservation goes beyond medical techniques. Financial planning, insurance, clinic selection, and psychological support are also important. Clinics like Mayo Clinic and Cleveland Clinic recommend pre-procedure counseling on vaccinations, chronic disease control, and folic acid to optimize outcomes.
Below is a compact comparison to guide initial discussions with a specialist. It highlights procedure steps, typical timelines, and practical trade-offs to inform age and fertility planning.
| Option | Key steps | Typical timeline | Main considerations |
|---|---|---|---|
| Egg freezing (oocyte cryopreservation) | Ovarian stimulation → egg retrieval → laboratory vitrification | 2–6 weeks per cycle; may need 1–3 cycles | Best when done younger; cost, storage, counseling on realistic success |
| Embryo freezing | Stimulation → retrieval → fertilization (partner or donor) → freeze | 2–6 weeks per cycle; embryo creation in same cycle | Higher success with younger eggs; requires sperm source and legal consent |
| Ovarian tissue freezing | Surgical removal of tissue → cryopreservation; later reimplantation or research use | Single surgical procedure; timeline varies for re-use | Experimental in many centers; option when immediate treatment is needed |
| Third-party options (donor gametes, surrogacy) | Donor selection → legal agreements → ART or gestational carrier processes | Varies widely; donor matching and legal work add months | Ethical, legal, and cost factors; counseling recommended for all parties |
Fertility treatment options by age and likely success rates
Choosing a fertility treatment means knowing what to expect. Age affects the options and success rates. Treatments vary from simple to complex, each with its own success rates and considerations.
Ovulation induction and IUI use medicines to help with fertility. This method works best for younger women or those with specific fertility issues. Success rates drop with age, especially for women over 40.
IVF is a key fertility treatment. It involves several steps to help fertilize eggs. Success rates depend on egg quality and age. Women over 40 have lower success rates, but IVF can use donor eggs to help.
Egg donation is an option when natural eggs are not viable. It uses eggs from a younger woman. This method is recommended for older women and those with low egg quality. It’s important to discuss the emotional and legal aspects of egg donation.
Third-party reproduction includes surrogacy and using donor sperm. Surrogacy requires legal and ethical counseling. It’s a good option for single parents and same-sex couples.
PGT checks embryos for genetic issues during IVF. It can improve success rates for older patients. Prenatal tests provide more information once a pregnancy is confirmed.
Counseling should give clear expectations and a personalized plan. Older women often need a combination of medical and emotional support. It’s important to discuss costs and provide ongoing support.
Additional resources to read:
What is the Male Factor in Infertility?
10 Natural Ways to Boost Fertility
Conclusion
Age and fertility are connected through biological changes. Ovarian reserve and egg quality decrease with age. Male fertility also declines, but more slowly.
Fertility starts to decline in the late 20s to early 30s. It speeds up after 35, with bigger drops in the 40s. These changes explain most cases of age-related infertility.
For those planning to have kids, it’s important to know the best time to do so. Younger people should think about family goals and career plans. Those waiting to have children might consider freezing eggs.
People over 35 should see a doctor after about six months of trying. They might need fertility tests or treatments sooner.
Those looking into ART or third-party reproduction need to understand success rates and options. They should also think about donor choices and legal aspects of surrogacy and donation.
Preconception care is crucial for reproductive health and aging. This includes managing health conditions and getting vaccinated. It’s also important to get clear, evidence-based advice for all involved.
Getting personalized care is essential. Talk to an Ob-Gyn or reproductive endocrinologist for a tailored plan. Use the latest advice from groups like the American Society for Reproductive Medicine and the American College of Obstetricians and Gynecologists to make informed decisions.
💫 Why Intended Parents Choose Complete Surrogacy for a Safe, Smooth & Successful Surrogacy Journey:
🌍 Access to multiple surrogacy destinations with 15+ years of international experience
🏥 Partnerships with top-tier fertility clinics and agencies, backed by references from past clients
👩🦱 Diverse egg donor options: Asian, Caucasian, African, Oriental, and more
💸 Transparent and affordable pricing—direct payments with no extra agency fees
🔒 No hidden costs—all charges are agreed upon upfront
🤝 Dedicated case manager for personalized support
📲 Fast, honest, and clear communication throughout
📑 Full legal support for visas, documentation, and baby exit processes
🚚 Assistance with frozen sperm/embryo shipment logistics

FAQ: Age and Fertility
What is the difference between egg quantity (ovarian reserve) and egg quality?
Egg quantity, or ovarian reserve, is how many eggs you have left. People born female have about 1–2 million eggs at birth. By puberty, this number drops to 300,000–500,000, and only about 300 eggs are actually ovulated over a lifetime. Egg quality is how likely an egg is to have the right number of chromosomes. As you get older, you have fewer eggs and more eggs with chromosomal problems, which can lead to miscarriage or birth defects.
When does fertility start to decline?
Fertility starts to decline before menopause. Menstrual cycles and ovulation are usually regular until the 20s. But, subtle declines in egg quantity and quality start in the late 20s to early 30s. By the late 30s and into the 40s, these declines are more noticeable, and natural conception rates drop a lot. Menopause usually happens around age 51, but fertility loss often starts 5–10 years earlier.
How does male fertility change with age?
Men keep producing sperm as they age, but the quality of the sperm declines. Sperm volume, motility, and shape get worse. Testes may also shrink and soften. Older dads have a slightly higher risk of genetic changes in their sperm, which can affect fertility. Medical conditions, medications, smoking, and lifestyle also play a role in sperm quality. A semen analysis is used to check male fertility.
What are the typical menstrual cycle changes as people age?
In reproductive years, cycles are usually 26–35 days with regular ovulation. As you get older, cycles may shorten to 21–25 days and then become irregular. Menopause is diagnosed after 12 months without a period. Hormonal changes cause these shifts.
How do age and fertility affect chances of conceiving per cycle?
The chance of getting pregnant naturally goes down with age. In the late teens and 20s, fertility is highest. By age 30, the chance of getting pregnant is about 20%. After 35, fertility drops faster, and by 40, chances are often below 5–10%. Both fewer eggs and more chromosomal problems in eggs contribute to this decline.
What are age-based risks for pregnancy complications?
Older moms face higher risks of pregnancy complications like preeclampsia, gestational diabetes, and preterm birth. They also have a higher chance of miscarriage and chromosomal disorders like Down syndrome. Preconception counseling and medical optimization are key for older prospective parents.
When should someone seek fertility evaluation?
If you’re under 35 and trying to conceive for 12 months without success, seek evaluation. For those 35 or older, start after 6 months. If you have obvious fertility issues, seek help right away. Early referral to a reproductive endocrinologist is advised if you have concerns.
What ovarian reserve tests are available and what do they show?
Tests include day-3 FSH and estradiol, antimüllerian hormone (AMH), and antral follicle count (AFC). These tests show if you have fewer eggs. They help plan treatment but can’t guarantee pregnancy.
How is male fertility evaluated?
Male fertility is checked with a semen analysis. This measures sperm concentration, motility, volume, and shape. If there are problems, a urologist or male reproductive specialist can help.
What diagnostic tests evaluate ovulation and reproductive anatomy?
Tests like cycle tracking, mid-luteal progesterone levels, and ultrasound check ovulation and reproductive anatomy. These tests help find causes of infertility and plan treatments.

Highly esteemed, authoritative, and trusted professional with a 14-year of experience in international surrogacy. Advocate for Secure, Legal, and Affordable International Surrogacy.
Neelam Chhagani, MA (Counselling Psychology) and Holistic Infertility and Third-Party Reproduction Consultant.
Member of European Fertility Society, Best Surrogacy Blogger of 2020, with 300 dedicated blogs, and top contributor on Quora for Surrogacy.

Add Your Comment